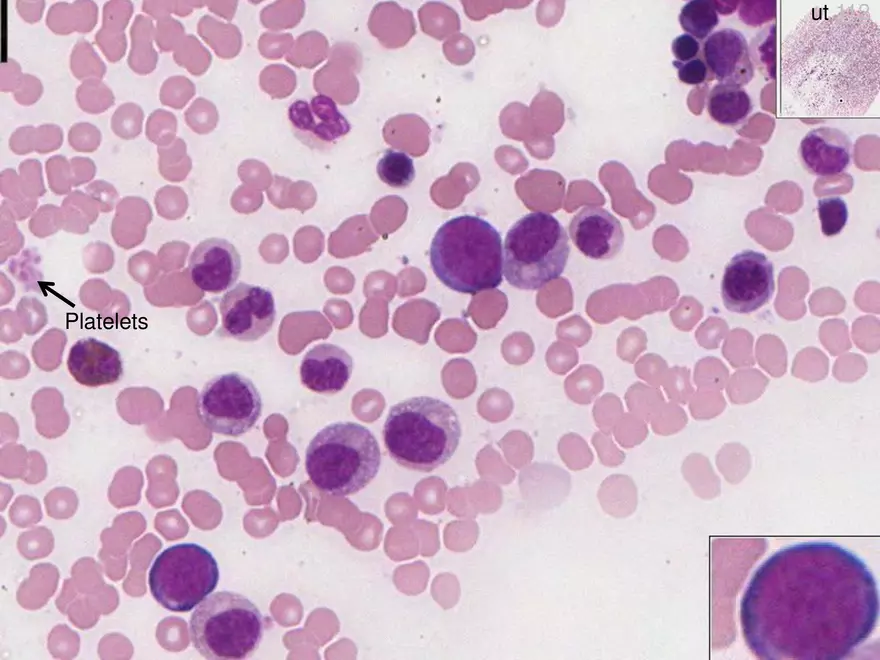

Study Guide
Peripheral Blood and Hematopoiesis Part 2 Hematopoiesis
-
University:
Texas A&M University -
Course:
BIOL 213 | Molecular Cell Biology Academic year:
2019
-
Views:
52
Pages:
58
Author:
Nossardisd7p
Related Documents
- Structure of Eukaryotic Cells
- General Information Classification & Marine Enviorments - Lecture Notes
- Etensions To Mendel's Laws - Chapter 3 Notes
- Final Review Lecture Notes
- Fish Stock Closed Systems & Detecting Change
- Costal Nitrogen - Lecture 2.11.19 Notes
- Muscle Study Materials
- Cell Shape and Size
- Sexual Reproduction in Humans
- Final Examination of Biostatistics for Premedical Students
- Connective Tissue Study Notes
- Contraction of Muscle
- Epithelial Tissue Study Materials
- Lecture: Cell History
- Introduction of Biology
- MCQ About Circulatory System
- Cell Parts, Structure and Function
- Organelles - Study Notes
- Plant Cells
- Tolerance Autoimmunity Test 1 Questions and Solutions
Report
Tell us what’s wrong with it:
Thanks, got it!
We will moderate it soon!
Report
Tell us what’s wrong with it:
Free up your schedule!
Our EduBirdie Experts Are Here for You 24/7! Just fill out a form and let us know how we can assist you.
Take 5 seconds to unlock
Enter your email below and get instant access to your document